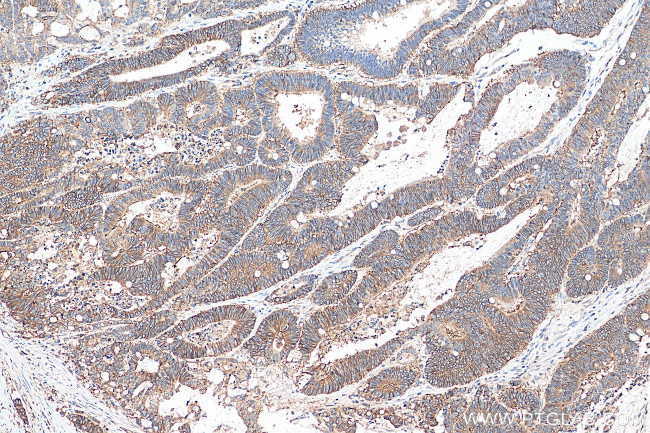
CD46 Antibody in Immunohistochemistry (Paraffin) (IHC (P))

Search
Proteintech
CD46 Polyclonal Antibody
{{$productOrderCtrl.translations['antibody.pdp.commerceCard.promotion.promotions']}}
{{$productOrderCtrl.translations['antibody.pdp.commerceCard.promotion.viewpromo']}}
{{$productOrderCtrl.translations['antibody.pdp.commerceCard.promotion.promocode']}}: {{promo.promoCode}} {{promo.promoTitle}} {{promo.promoDescription}}. {{$productOrderCtrl.translations['antibody.pdp.commerceCard.promotion.learnmore']}}
产品信息
28936-1-AP
种属反应
宿主/亚型
分类
类型
抗原
偶联物
形式
浓度
规格
纯化类型
保存液
内含物
保存条件
运输条件
产品详细信息
Aliquoting is unnecessary for -20°C storage.
靶标信息
CD46 (MCP, membrane cofactor protein) is a multifunctional cell surface transmembrane protein that binds and inactivates C3b and C4b complement fragments, regulates T cell-induced inflammatory responses by either inhibiting (CD46-1 isoform) or increasing (CD46-2 isoform) the contact hypersensitivity reaction. CD46 also serves as a receptor for several human pathogens (both bacteria and viruses), and its ligation alteres T lymphocyte polarization toward antigen-presenting cells or target cells, inhibiting lymphocyte function. CD46 is a protector of placental tissue and is also expressed on the inner acrosomal membrane of spermatozoa.
仅用于科研。不用于诊断过程。未经明确授权不得转售。
篇参考文献 (0)
生物信息学
蛋白别名: antigen identified by monoclonal antibody TRA-2-10; CD46; CD46 antigen, complement regulatory protein; CD46 molecule, complement regulatory protein; complement membrane cofactor protein; measles virus receptor; Membrane cofactor protein; membrane cofactor protein (CD46, trophoblast-lymphocyte cross-reactive antigen); MGC26544; TLX; trophoblast leucocyte common antigen; Trophoblast leukocyte common antigen; trophoblast-lymphocyte cross-reactive antigen; unnamed protein product
基因别名: AHUS2; CD46; MCP; MIC10; TLX; TRA2.10
UniProt ID: (Human) P15529
Entrez Gene ID: (Human) 4179